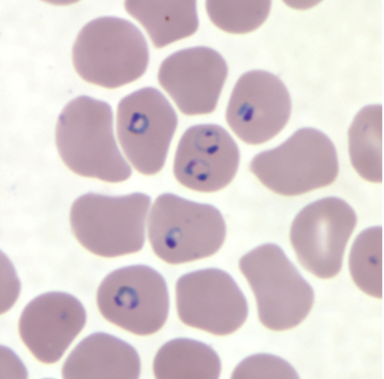
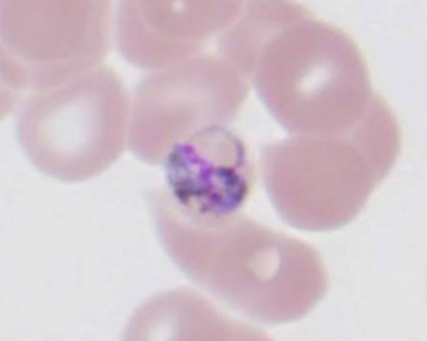
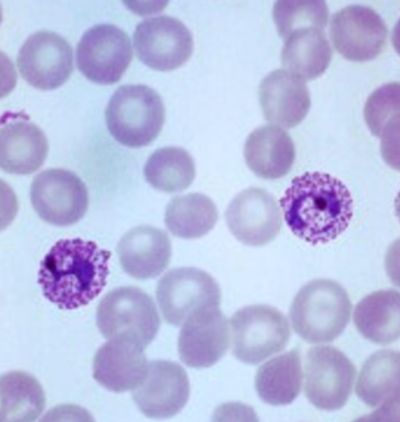
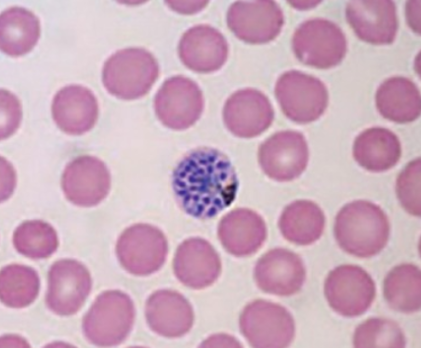
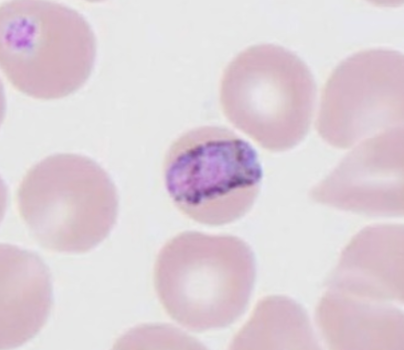
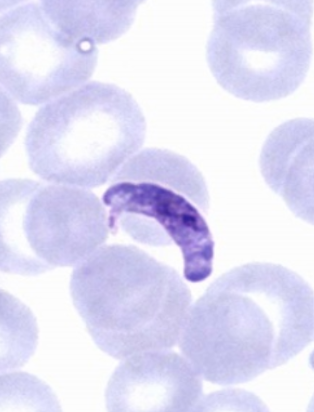
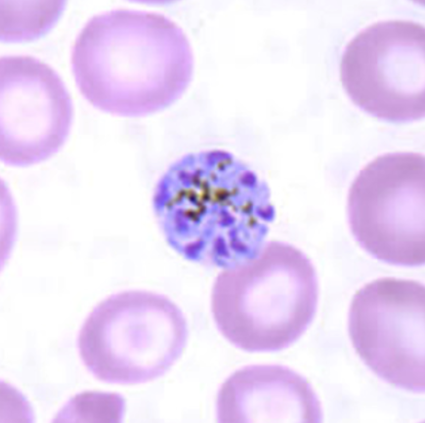

Parasitology Lab Exam 1
1/74
Earn XP
Description and Tags
who's that pokemon? but for parasites
Name | Mastery | Learn | Test | Matching | Spaced |
|---|
No study sessions yet.
75 Terms
what’s this?
P. falciparum, trophozoite, ring stage
what’s this?
P. malariae, trophozoite, basket form
what’s this?
P. vivax, trophozoite, Schuffner’s dots
what’s this?
P. falciparum, schizont
what’s this?
P. malariae, trophozoite, band form
what’s this?
P. falciparum, gametocyte
what’s this?
P. malariae, schizont, rosette form

whats this
ciliates doing conjugation

whats this
promastigote

whats this
Trypanosoma brucei trypomastigotes

whats this
Giardia duodenalis

whats this
Giardia duodenalis

whats this
Trichomonas vaginalis

whats this
Trophozoites of Trichomonas vaginalis

whats this
Trophozoites of Entamoeba histolytica

whats this
Trophozoites of Entamoeba histolytica

whats this
Entamoeba histolytica

whats this
Entamoeba histolytica mature cyst

whats this
Entamoeba histolytica Trophozoites

whats this
Trophozoite of Entamoeba coli

whats this?
Trophozoite of Entamoeba coli

whats this
Entamoeba coli mature cyst

whats this
Entamoeba coli mature cyst

whats this
Entamoeba coli immature cyst

whats this
Naegleria fowleri trophozoites

whats this
Acanthamoeba trophozoite

what are these
Acanthamoeba spp. cysts

whats this
Trophozoites of Balantidium coli

whats this
Balantidium coli trophozoite

whats this
Balantidium coli cyst

whats this
Leishmania promastigote

whats this
L. donovani amastigote

whats this?
Monocystis sp. sporocyst

whats this
Monocystis sp. trophozoite

whats this
Monocystis lumbrici gametocyst with oocysts

whats this
Cephaline gregarines in syzygy.
(P=protomerite; D=deutomerite)

whats this
Paramecium fission

whats this
Paramecium conjugation

whats this
Euglena

whats this
Leishmania amastigotes
Which has a centrally located endosome in the nucleus?
Entamoeba histolytica has a centrally located endosome

whats this
Eimeria, unsporulated oocyst

whats this
Eimeria, unsporulated oocyst

whats this (A)
Eimeria, sporulated oocyst (A)

whats this
Eimeria, sporulated oocyst
how many sporozoites per eimeria oocyst
eight infectious sporozoites per sporulated oocyst
An Eimeria oocyst contains ___
four sporocysts

An Eimeria sporocyst contains ___
two sporozoites

what is the “mouth” on the giardia duodenalis
median body

What is the outside of the “eyes” on the giardia duodenalis
adhesive disk

What is the big bean in balantidium coli
macronucleus

what is the vector for tb brucei, tb gambiense, and tb rhodiesiense
tsetse fly, genus Glossina
what is the vector for chagas disease
kissing bug, family Reduviidae
the kissing bug deposits the ___ in feces
metacyclic form
what is the vector for Leishmaniasis
female sandfly, family psychodidae
what is the single point on trichomonas vaginalis
axostyle

what are the 4 anterior flagella trichomonas vaginalis
flagellar tuft

whats this
genus Acanthamoeba
what is a key feature of infective stages of something like malaria?
apical complex

what is the vector for malaria
female anopheline mosquito, genus Plasmodium
what is the vector for babesia bigemina
tick, genus Rhipicephalus

whats this
babesia bigemina
babesia bigemina infects ___
ruminants
what is the vector for babesia microti
blacklegged tick, genus Ixodes
babesia microti infects ___
humans, causing lyme
Lyme disease bacteria is aka
borrelia burgdorferi

whats this
babesia microti
East Coast fever
Theileria parva
tropical theileriosis
Theileria annulata
What genus of tick-borne protozoan parasites causes disease in mammals, particularly cattle, sheep, and goats
genus Theileria

whats this
genus Theileria
what parasite causes toxoplasmosis
Toxoplasma gondii
what is the vector for toxoplasma gondii
cat, genus felis

whats this
toxoplamosis
what parasite causes cyclosporiasis
Cyclospora cayetanensis